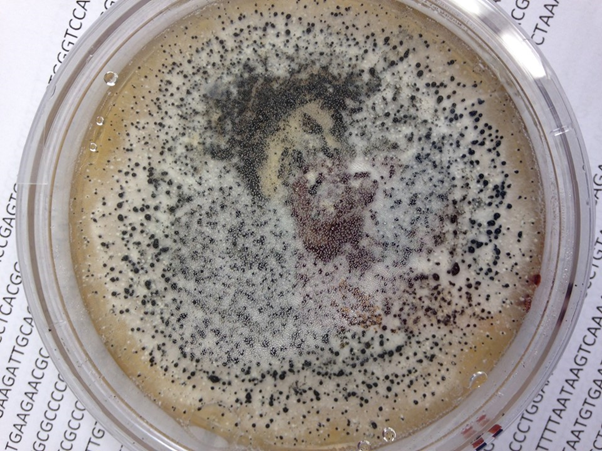
腐生海洋真菌

腐生螨

【转载】一种顽固的小虫腐生螨
图片尺寸700x467
腐生条件(霉菌是寄生还是腐生)
图片尺寸640x480
腐食酪螨
图片尺寸220x173
根霉是显微镜下教育植物上常见的腐生真菌属.
图片尺寸1200x800
根霉(面包霉)是一种常见的腐生真菌,显微镜下的根霉(面包霉).
图片尺寸1200x800
根霉(面包霉)是一种常见的腐生真菌,显微镜下的根霉(面包霉).
图片尺寸1200x800
腐生海洋真菌
图片尺寸602x451
根霉(面包霉)是一种常见的腐生真菌,显微镜下的根霉(面包霉).
图片尺寸1200x800
腐生真菌
图片尺寸1200x775
辨识380味中药拔毒化腐生肌药
图片尺寸786x786
其它 黄氏祛腐生肌膏(副本) 写美篇传承古方手工产
图片尺寸1057x1766
病虫害科普丨螨类的危害与防治
图片尺寸800x600
时间久的疤痕一直不愈合,称之为经久不愈的伤口,用上古方药油加生肌膏
图片尺寸1080x931
马应龙 龙珠软膏10g /支 祛腐生肌轻度烫伤 1盒装
图片尺寸800x800
中医祛腐生肌河南糖尿病足患者不截肢痊愈
图片尺寸1080x810
柑橘锈瘿螨词条图册_百度百科
图片尺寸400x298
链格孢霉菌
图片尺寸633x442
魑魅魍魉.去腐生肌#实话实说传递正能量 #人民至上不忘初心 - 抖音
图片尺寸618x1060
褥疥灵祛腐生肌乳膏抑菌护肤祛除腐肉褥疮压疮缓解痛痒促进愈合
图片尺寸800x800
腐生条件(霉菌是寄生还是腐生)
图片尺寸618x402